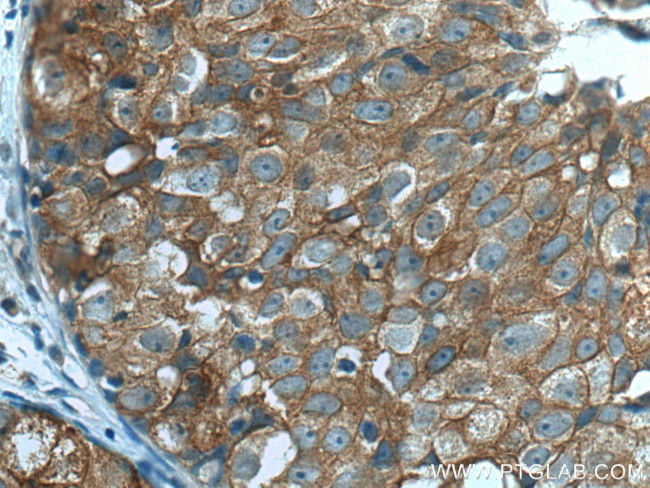
IFNGR2 Antibody in Immunohistochemistry (Paraffin) (IHC (P))

Search
Proteintech
IFNGR2 Polyclonal Antibody
{{$productOrderCtrl.translations['antibody.pdp.commerceCard.promotion.promotions']}}
{{$productOrderCtrl.translations['antibody.pdp.commerceCard.promotion.viewpromo']}}
{{$productOrderCtrl.translations['antibody.pdp.commerceCard.promotion.promocode']}}: {{promo.promoCode}} {{promo.promoTitle}} {{promo.promoDescription}}. {{$productOrderCtrl.translations['antibody.pdp.commerceCard.promotion.learnmore']}}
产品信息
10266-1-AP
种属反应
已发表种属
宿主/亚型
分类
类型
抗原
偶联物
形式
浓度
规格
纯化类型
保存液
内含物
保存条件
运输条件
产品详细信息
Immunogen sequence: AWVTMPWFQ HYRNVTVGPP ENIEVTPGEG SLIIRFSSPF DIADTSTAFF CYYVHYWEKG GIQQVKGPFR SNSISLDNLK PSRVYCLQVQ AQLLWNKSNI FRVGHLSNIS CYETMADAST ELQQVILISV GTFSLLSVLA GACFFLVLKY RGLIKYWFHT PPSIPLQIEE YLKDPTQPIL EALDKDSSPK DDVWDSVSII S (125-324 aa encoded by BC003624)
靶标信息
This gene (IFNGR2) encodes the non-ligand-binding beta chain of the gamma interferon receptor. Human interferon-gamma receptor is a heterodimer of IFNGR1 and IFNGR2. Defects in IFNGR2 are a cause of mendelian susceptibility to mycobacterial disease (MSMD), also known as familial disseminated atypical mycobacterial infection. MSMD is a genetically heterogeneous disease with autosomal recessive, autosomal dominant or X-linked inheritance.
仅用于科研。不用于诊断过程。未经明确授权不得转售。
生物信息学
蛋白别名: AF-1; IFN-gamma receptor 2; IFN-gamma-R-beta; IFN-gamma-R2; IFNgR2; Interferon gamma receptor 2; Interferon gamma receptor accessory factor 1; interferon gamma receptor accessory factor-1; interferon gamma receptor beta chain; Interferon gamma receptor beta-chain; Interferon gamma transducer 1; unnamed protein product
基因别名: AF-1; IFGR2; IFNGR2; IFNGT1; IMD28
UniProt ID: (Human) P38484
Entrez Gene ID: (Human) 3460